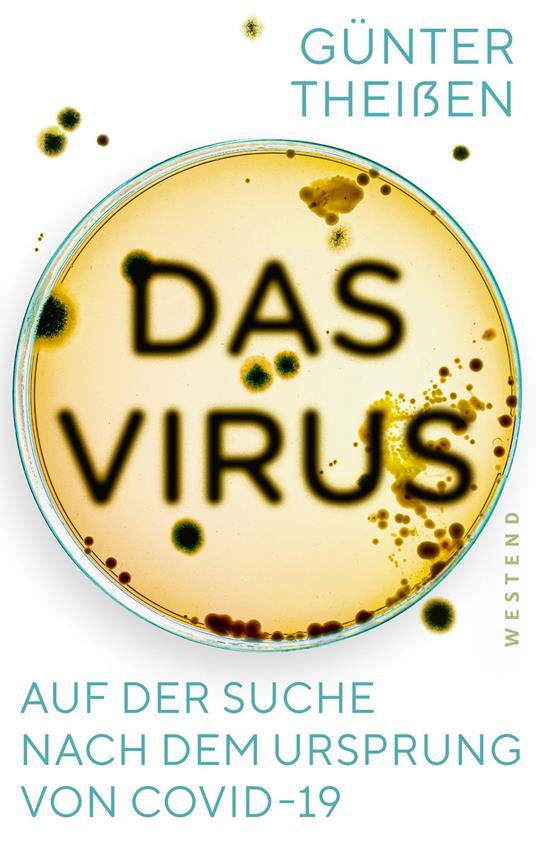
Das Virus

L’articolo è stato aggiunto alla lista dei desideri
IBS.it, l'altro eCommerce
Das Virus
Cliccando su “Conferma” dichiari che il contenuto da te inserito è conforme alle Condizioni Generali d’Uso del Sito ed alle Linee Guida sui Contenuti Vietati. Puoi rileggere e modificare e successivamente confermare il tuo contenuto. Tra poche ore lo troverai online (in caso contrario verifica la conformità del contenuto alle policy del Sito).
Grazie per la tua recensione!
Tra poche ore la vedrai online (in caso contrario verifica la conformità del testo alle nostre linee guida). Dopo la pubblicazione per te +4 punti
Altre offerte vendute e spedite dai nostri venditori



Tutti i formati ed edizioni
Promo attive (0)
Die Corona-Pandemie bringt nicht nur Politiker auf absonderliche Gedanken, sondern auch Kabarettisten. Während erstere die Demokratie und das Grundgesetz mit Panik-Maßnahmen durchlöchern, versucht der Kabarettist Mathias Richling mit diesem Buch zu retten, was noch zu retten ist. Es gilt die Herden-Immunität gegen unsere Demokratie zu verhindern. So ist dieses Buch nicht nur eine scharfsinnige Bestandsaufnahme darüber, was das Covid19-Virus an psychischen und physischen Langzeitfolgen für unsere Gesellschaft anrichtet, sondern auch ein Appell an unsere Wachsamkeit gegenüber vorauseilendem Gehorsam sowohl an der Basis als auch in Wissenschaft und Politik.
L'articolo è stato aggiunto al carrello
Formato:
Gli eBook venduti da IBS.it sono in formato ePub e possono essere protetti da Adobe DRM. In caso di download di un file protetto da DRM si otterrà un file in formato .acs, (Adobe Content Server Message), che dovrà essere aperto tramite Adobe Digital Editions e autorizzato tramite un account Adobe, prima di poter essere letto su pc o trasferito su dispositivi compatibili.
Cloud:
Gli eBook venduti da IBS.it sono sincronizzati automaticamente su tutti i client di lettura Kobo successivamente all’acquisto. Grazie al Cloud Kobo i progressi di lettura, le note, le evidenziazioni vengono salvati e sincronizzati automaticamente su tutti i dispositivi e le APP di lettura Kobo utilizzati per la lettura.
Clicca qui per sapere come scaricare gli ebook utilizzando un pc con sistema operativo Windows
L’articolo è stato aggiunto alla lista dei desideri